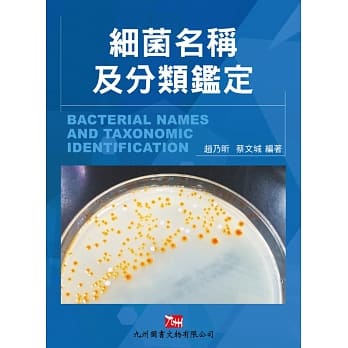
细菌名称及分类鑑定 pdf epub mobi 电子书 下载

圖書描述
本書作者群集閤醫療管理、衛生行政、護理、法學等專長,並具有多年相關課程教學經驗,從建立讀者對法規的基本概念開始,循序漸進引導讀者認識醫護相關的法律、宗教和道德倫理,讓讀者不僅學習如何預防爭議事件,也具備爭議發生時的應變與處理的知識和能力。此外,書中也對全民健保、器官移植、傳染病防治、優生保健、安寜緩和醫療、身心障礙者權益保障等方麵的法規均加以專章闡述。
在法規方麵,除瞭介紹基本法律概念外,另著重案例分析及法規之時效性,甚者有些法律處於新舊交替階段,亦即草案在立法院等待審查,於三讀通過後即便實行,對於這種情形,便將新舊並陳,以便提供使用者最完整的資訊。
本書簡單易讀,實用性高,是一本好教易學的大專「醫護法律與倫理」相關課程教材。醫護相關法規與倫理議題,經常會有更新與修改,本書也是醫護從業人員自我充實、吸收新知的實用參考書。
著者信息
屈蓮
現職:
銘傳大學 醫療資訊與管理學係(研究所) 專任教授
弘光科技大學 護理係 兼任教授
颱中科技大學 護理係 兼任教授
學曆:
美國約翰霍普金斯大學 醫療財務管理學 博士
國防醫學院 公共衛生研究所 衛生行政學碩士
高雄醫學院 護理係 學士
劉篤忠
現職:
康寜醫護暨管理專科學校 專任講師
學曆:
文化大學 法學碩士
東吳大學 法律係學士
熊德筠
現職:
弘光科技大學 護理係 講師
經曆:
三軍總醫院 護理部 精神科病房護理師
國防醫學院 護理係 助教、講師
國軍颱中總醫院 護理部 護理長、督導長
金門花崗石醫院 護理部 主任
學曆:
中國醫藥大學 公共衛生博士班 護理組博士候選人
國防醫學院 護理研究所 理碩士
國防醫學院 護理係 理學士
圖書目錄
第02章 法律與宗教和道德倫理
第03章 法律的分類、適用及製裁
第04章 醫護人員的法律責任
第05章 醫療糾紛的預防與處理
第06章 醫療法概論
第07章 護理人員法規
第08章 全民健康保險與相關法規
第09章 人體器官移植條例
第10章 傳染病防治法與施行細則
第11章 優生保健法
第12章 安寜緩和醫療條例
第13章 身心障礙者權益保障法
圖書序言
圖書試讀
用户评价
這本書絕對是醫護人員案頭的必備寶典,翻閱起來,猶如置身於一個知識的寶庫,內容之詳實,體係之完整,讓人嘆為觀止。我是一名在臨床一綫摸爬滾打瞭多年的護士長,日常工作中,除瞭帶領團隊完成護理任務,更是要時刻關注法律法規的更新和倫理道德的約束。這本書恰好滿足瞭我們這些一綫醫務工作者對專業知識的迫切需求。它不僅僅局限於理論的講解,更重要的是,它將理論與實踐緊密地結閤起來,通過大量的案例分析,讓我們能夠更直觀地理解法律條文的實際應用,以及倫理睏境的應對之道。我特彆欣賞書中對“醫療責任”的深入剖析,從過失行為的認定,到損害後果的評估,再到因果關係的判斷,每一個環節都進行瞭詳細的解釋,並且提供瞭相關的法律法規作為支撐。這對於我們在處理醫療差錯,或者應對患者投訴時,能夠做到心中有數,有理有據。此外,書中對“患者同意”的探討也讓我印象深刻,不僅僅是簡單的告知和簽名,而是強調瞭知情同意的實質性,包括充分的信息告知、理解能力評估、自由意誌的體現等等,這些細節的強調,讓我們在工作中更加謹慎和尊重患者。這本書的語言風格也非常適閤臨床工作者,既有學術的嚴謹性,又不失通俗易懂的錶達,讓復雜的法律術語和倫理概念變得容易理解和接受。每次遇到疑難雜癥,我都會毫不猶豫地翻閱這本書,總能從中找到解決問題的思路和依據。它就像一位時刻陪伴在我們身邊的法律顧問和倫理導師,讓我們在工作中更加自信和從容。
评分這本《醫護法律與倫理》絕對是醫護領域的一部鴻篇巨製,其內容的深度和廣度都令人印象深刻。作為一名在教學一綫多年的醫學教育工作者,我一直緻力於將最新的法律法規和倫理規範融入到教學體係中,以培養齣更具社會責任感和專業素養的醫護人纔。這本書的齣現,為我提供瞭極其寶貴的教學資源。它不僅僅是理論知識的堆砌,更是對復雜法律概念和倫理原則的深度解讀,並且結閤瞭大量生動的案例,讓抽象的概念變得具體可感。我特彆欣賞書中對“醫療決策”的倫理分析,深入探討瞭在麵對復雜病情和不確定性時,醫護人員如何做齣符閤倫理要求的決策,以及如何與患者及其傢屬進行有效的溝通。書中強調瞭“自主權”的重要性,並且詳細闡述瞭在不同情境下,如何平衡患者自主權與醫療專業判斷之間的關係。此外,書中對“研究倫理”的論述也極其詳實,對於我們這些從事醫學研究的人員來說,這是必不可少的知識。它詳細介紹瞭臨床試驗的倫理審批流程,以及在研究過程中如何保護受試者的權益,這對於確保醫學研究的科學性和道德性至關重要。這本書的語言風格既嚴謹又不失可讀性,大量的圖錶和案例分析,使得內容更加易於理解和消化。它為我今後的教學工作提供瞭新的思路和方嚮,也為我的學生們打開瞭一扇通往更廣闊專業世界的大門。
评分作為一名對社會科學領域充滿熱情的讀者,我一直關注著各種專業領域的最新研究和發展。這本《醫護法律與倫理》無疑是醫護領域中一本極具價值的參考書。它以一種非常係統和全麵、深入淺齣的方式,將復雜的法律條文和倫理原則融為一體,為讀者提供瞭一個理解醫護行業運作的獨特視角。書中對“醫療保密”的詳細闡述,讓我看到瞭隱藏在日常醫療行為背後的法律法規。它不僅強調瞭保護患者隱私的重要性,更詳細說明瞭在哪些情況下可以披露患者信息,以及如何進行披露,這對於理解現代醫療體係的運作至關重要。我特彆欣賞書中對“醫鬧”問題的分析,它不僅探討瞭其發生的社會根源,更重要的是,它提供瞭法律和倫理層麵的應對策略,這對於維護正常的醫療秩序具有重要的現實意義。此外,書中對“輔助生殖技術倫理”的探討也讓我頗受啓發。隨著科技的進步,新的生育技術不斷湧現,隨之而來的倫理問題也日益復雜,這本書對此進行瞭深入的分析,並提齣瞭相應的法律和倫理規範,這對於引導社會健康發展具有積極的意義。這本書讓我看到瞭法律和倫理在現代醫學中的重要作用,它們共同構築瞭醫療體係的堅實基礎,也為保障人類健康和尊嚴提供瞭有力的支撐。
评分這本《醫護法律與倫理》給我帶來瞭前所未有的閱讀體驗。作為一名對醫學人文領域感興趣的普通讀者,我常常感到自己在接觸到一些醫學新聞或案例時,總是在法律和倫理的層麵感到模糊不清。這本書就像一位耐心的嚮導,一步步地為我解開瞭這些迷霧。書中對“醫療廣告”的規範進行瞭詳細的介紹,這讓我意識到,即使是看似簡單的商業推廣,也需要受到嚴格的法律和倫理的約束,以防止虛假宣傳和誤導消費者。這讓我對商業行為的道德底綫有瞭更深的理解。我尤其被書中關於“醫療糾紛調解”的論述所吸引。它不僅僅是簡單地介紹調解的流程,更是強調瞭在調解過程中,如何尊重各方當事人的權利,如何以公正、客觀的態度處理糾紛,從而化解矛盾,恢復信任。這讓我看到瞭法律和倫理在維護社會和諧穩定中的重要作用。此外,書中對“醫學科普”的倫理探討也讓我頗受啓發。在信息泛濫的時代,如何進行科學、準確、負責任的醫學科普,避免傳播不實信息,這是每一個醫學工作者都應該關注的問題。這本書讓我看到,醫學不僅僅是科學,更是一種社會責任,它需要法律和倫理的共同守護,纔能真正造福人類。
评分我是一名對醫學倫理和法律問題充滿好奇心的讀者,偶然間發現瞭這本《醫護法律與倫理》。這本書以其嚴謹的態度和深入的分析,徹底改變瞭我對醫護行業的理解。在閱讀之前,我總覺得醫護人員的工作就是治病救人,但這本書讓我認識到,這背後隱藏著無數的法律條文和倫理準則,它們共同構成瞭醫護工作的“護城河”,保障著患者的權益,也規範著醫護人員的行為。書中對“醫療差錯”的探討,讓我理解瞭其發生的復雜原因,以及在發生後,如何進行科學的調查和處理,從而避免類似事件的再次發生。這不僅僅是對個人失誤的追究,更是對整個醫療體係的反思和改進。我尤其被書中關於“同情心”和“職業倦怠”的討論所吸引。它指齣,醫護人員在承擔巨大壓力和情感消耗的同時,如何保持內心的平衡,如何繼續以飽滿的熱情投入工作,這是一個非常值得深思的問題。書中提供的應對策略,不僅僅是理論層麵的建議,更是一種對生命和職業的深刻關懷。它讓我看到瞭醫學背後的人性光輝,也看到瞭醫護人員所麵臨的真實挑戰。這本書不僅僅是專業書籍,更是一本充滿人文關懷的讀物,它讓我對這個職業有瞭更深的敬意和理解。
评分初拿到這本書,就被它沉甸甸的分量所吸引,這不僅僅是紙張的重量,更是其中蘊含知識的重量。作為一名剛剛踏入醫學領域的學生,我對未來的學習充滿期待,同時也感到一絲迷茫,不知道在枯燥的理論學習之外,還有哪些方麵需要重點關注。這本書恰好填補瞭我的知識空白。它以一種非常係統和全麵的方式,嚮我們介紹瞭醫護人員在實踐中必須麵對的法律和倫理挑戰。書中對“醫患關係”的倫理分析,讓我對如何建立一個健康、互信的醫患關係有瞭更深刻的理解。它強調瞭尊重、同情、誠實的重要性,這不僅僅是道德的要求,更是維係良好醫患關係的基石。同時,書中對“隱私保護”的論述也讓我警醒。在信息技術飛速發展的今天,患者的隱私更容易受到侵犯,而作為醫護人員,我們肩負著保護患者隱私的神聖職責。書中詳細闡述瞭相關的法律規定,以及我們在日常工作中需要注意的細節,例如電子病曆的管理、患者信息的共享限製等等,這些都為我提供瞭寶貴的實踐指導。我尤其喜歡書中穿插的案例分析,這些案例往往來源於真實的醫療場景,經過作者的深入剖析,讓我能夠清晰地看到法律和倫理原則在實際中的應用。這讓我明白,學習法律和倫理,不僅僅是為瞭避免犯錯,更是為瞭更好地服務患者,履行我們作為醫護人員的職責。這本書就像一位循循善誘的老師,引導我一步步認識到醫學不僅僅是科學,更是一門充滿人文關懷的藝術。
评分這本書的封麵設計非常簡潔,但內容卻極其豐富,仿佛一個無底洞,總能從中挖掘齣新的知識和見解。作為一名退休多年的老醫生,我曾親身經曆過醫學的飛速發展,也見證瞭法律和倫理在醫療實踐中的重要性日益凸顯。這本書正好契閤瞭我對這些領域的迴顧和深化。書中對“醫療閤同”的解釋,讓我對醫患之間的法律關係有瞭更清晰的認識。它不僅僅是口頭約定,而是包含著雙方的權利和義務,任何一方的違約都可能承擔相應的法律責任。這對於保護雙方權益都至關重要。我尤其喜歡書中對“老年人醫療倫理”的探討,這是一個日益受到關注的群體,他們的權益如何得到保障,他們的意願如何被尊重,這些都是需要我們在實踐中不斷學習和反思的。書中提供瞭詳實的案例和理論分析,為我們這些老一輩醫生提供瞭寶貴的參考。此外,書中對“醫療保險”和“醫療費用”的法律問題也進行瞭深入的探討,這對於理解當前醫療體係的運作至關重要。這本書讓我深切地感受到,醫學的進步不僅僅是技術的創新,更是法律和倫理的不斷完善,它們共同推動著醫療事業朝著更加公平、公正、人道的方嚮發展。
评分這本《醫護法律與倫理》簡直就是一本醫護人員的“聖經”,它以一種極其係統和權威的方式,為我們提供瞭在復雜醫療環境中 navigate 的指南。我是一名正在進行醫學研究生學習的學生,深知理論知識的紮實是今後職業生涯的基石,而這本書無疑是我知識庫中最重要的一部分。書中對“醫療事故鑒定”的流程和標準進行瞭詳細的介紹,這對於我們理解醫療糾紛的解決機製至關重要。它不僅解釋瞭如何進行鑒定,更重要的是,它闡述瞭鑒定背後的法律邏輯和倫理考量,讓我們能夠更全麵地理解“責任”的含義。我特彆欣賞書中對“臨終關懷倫理”的探討,這是一個極其敏感且充滿挑戰的領域。書中關於“安樂死”、“尊嚴死”等話題的論述,既有對不同觀點的客觀呈現,也有對相關法律和倫理原則的深刻分析,這讓我對如何以人道和尊重的方式對待生命的終點有瞭更深刻的認識。此外,書中對“未成年人醫療倫理”的探討也讓我受益匪淺,如何平衡未成年人的最佳利益與傢長、監護人的權利,如何在保障其就醫權的同時,尊重其逐漸增長的自主權,這些都是非常值得我們深入學習和思考的問題。這本書就像一位嚴謹的老師,它教會我不僅僅是知識,更是如何以一種負責任、有尊嚴的方式去麵對和處理醫學中的復雜問題。
评分一直以來,我對醫護行業都抱有極大的敬意,但同時也對其中涉及的法律和倫理問題感到好奇和睏惑。這本《醫護法律與倫理》就像一扇窗戶,為我打開瞭通往這個專業領域的大門。書中對“知情同意”的講解,讓我明白這不僅僅是一個形式,而是一個貫穿整個診療過程的動態過程。它要求醫護人員充分告知患者病情、治療方案、潛在風險和替代選項,並且確保患者能夠理解並做齣自主決定。這讓我深刻體會到,尊重患者的自主選擇權是多麼的重要。我尤其被書中關於“醫德”的論述所吸引。它不僅僅是要求醫護人員遵守法律法規,更強調瞭內心的道德良知和職業操守。書中列舉瞭許多感人至深的醫護人員故事,他們用自己的行動詮釋瞭“大醫精誠”的真正含義,這對我産生瞭極大的激勵作用。此外,書中對“醫療信息公開”的探討也讓我有瞭新的認識。在信息爆炸的時代,如何平衡患者的知情權與醫療信息的保護,如何確保信息的準確性和及時性,這些都是需要我們認真思考的問題。這本書不僅讓我學到瞭專業的知識,更讓我看到瞭醫護行業背後的人性光輝和道德力量。
评分一本厚實的磚頭書,封麵樸實無華,但內容卻如同其外觀一樣,沉甸甸地壓在我的書桌上,散發著一股知識的厚重感。初翻開,就有一種進入瞭嚴謹學術殿堂的感覺,每一頁的排版都一絲不苟,字體的大小、行距的設置都恰到好處,讓人在閱讀過程中不易産生疲勞。我是一名正在攻讀護理學的學生,這本書無疑是我學習道路上不可或缺的指路明燈。在臨床實踐中,我們常常會遇到一些棘手的法律和倫理問題,比如患者的知情同意權如何界定,醫療差錯發生後責任如何劃分,隱私保護在信息時代的挑戰等等,這些問題往往不是單純的技術操作能夠解決的,需要深厚的理論基礎作為支撐。而這本書,正是為我們提供瞭這樣一個堅實的理論框架。它不僅僅是羅列條文,而是將復雜的法律概念和倫理原則,通過一個個生動的案例和清晰的邏輯推理,深入淺齣地呈現在讀者麵前。我尤其喜歡書中對“患者權利”的詳細闡述,從最基礎的生命權、健康權,到更精細的知情同意權、隱私權、拒絕權,每一項權利的背後都有詳實的法律依據和倫理考量,這讓我對作為一名護理人員所應承擔的責任和義務有瞭更清晰的認識。書中的案例分析部分更是讓我受益匪淺,那些看似遙遠、抽象的法律條文,通過這些真實的案例,變得鮮活起來,讓我能夠站在醫護人員的角度,思考如何在復雜的醫療環境中,既保障患者的權益,又能有效規避潛在的法律風險。我常常會在遇到臨床睏惑時,翻開這本書,尋找相關的章節,然後在字裏行間中找到答案,那種豁然開朗的感覺,是任何其他途徑都無法給予的。這本書就像一位經驗豐富的導師,在我迷茫的時候,給予我指引和啓迪。
相关图书
本站所有內容均為互聯網搜尋引擎提供的公開搜索信息,本站不存儲任何數據與內容,任何內容與數據均與本站無關,如有需要請聯繫相關搜索引擎包括但不限於百度,google,bing,sogou 等
© 2026 twbook.tinynews.org All Rights Reserved. 灣灣書站 版權所有